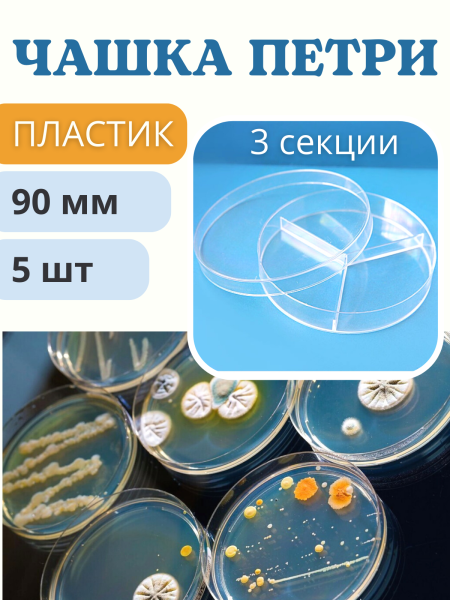
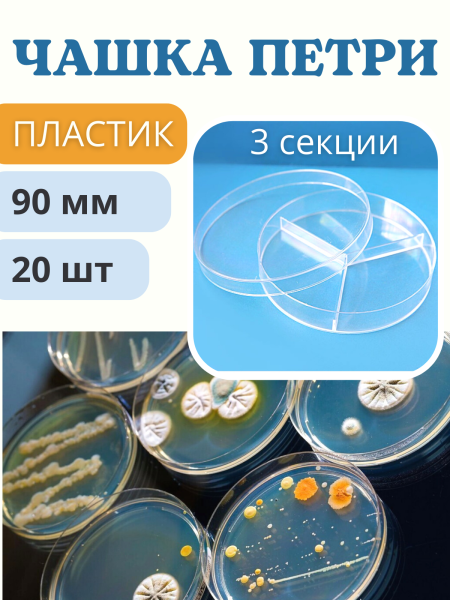
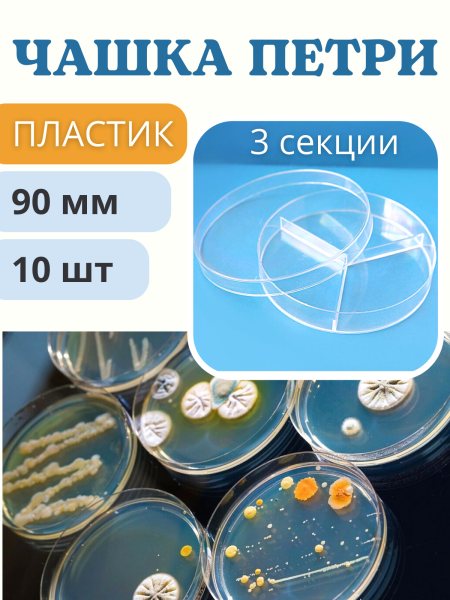

Старая цена
150 ₽/шт
Цена
115 ₽/шт
Клубная цена
81 ₽/шт
Старая цена
210 ₽/шт
Цена
170 ₽/шт
Клубная цена
111 ₽/шт
Старая цена
450 ₽/шт
Цена
395 ₽/шт
Клубная цена
246 ₽/шт
Старая цена
160 ₽/шт
Цена
130 ₽/шт
Клубная цена
88 ₽/шт
Старая цена
430 ₽/шт
Цена
415 ₽/шт
Клубная цена
235 ₽/шт
Старая цена
250 ₽/шт
Цена
235 ₽/шт
Клубная цена
136 ₽/шт
Старая цена
30 ₽/шт
Цена
15 ₽/шт
Клубная цена
14 ₽/шт
Старая цена
200 ₽/шт
Цена
170 ₽/шт
Клубная цена
109 ₽/шт
Старая цена
560 ₽/шт
Цена
525 ₽/шт
Клубная цена
306 ₽/шт
Старая цена
310 ₽/шт
Цена
295 ₽/шт
Клубная цена
170 ₽/шт
Достаточно
Старая цена
40 ₽/шт
Цена
20 ₽/шт
Клубная цена
19 ₽/шт
Старая цена
90 ₽/шт
Цена
60 ₽/шт
Клубная цена
45 ₽/шт
Достаточно
Старая цена
150 ₽/шт
Цена
115 ₽/шт
Клубная цена
78 ₽/шт
Старая цена
160 ₽/шт
Цена
120 ₽/шт
Клубная цена
87 ₽/шт
Старая цена
110 ₽/шт
Цена
80 ₽/шт
Клубная цена
60 ₽/шт
Цена
650 ₽/шт
Клубная цена
376 ₽/шт
Старая цена
120 ₽/шт
Цена
85 ₽/шт
Клубная цена
66 ₽/шт
Старая цена
490 ₽/шт
Цена
420 ₽/шт
Клубная цена
267 ₽/шт
Старая цена
210 ₽/шт
Цена
155 ₽/шт
Клубная цена
114 ₽/шт
Старая цена
200 ₽/шт
Цена
140 ₽/шт
Клубная цена
109 ₽/шт
.jpeg)


.png)

.webp)


















